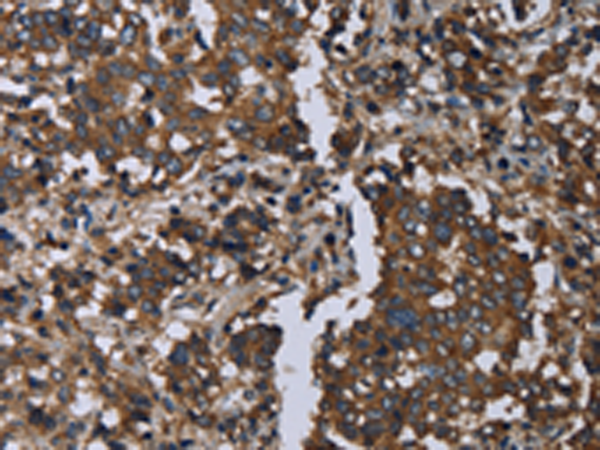
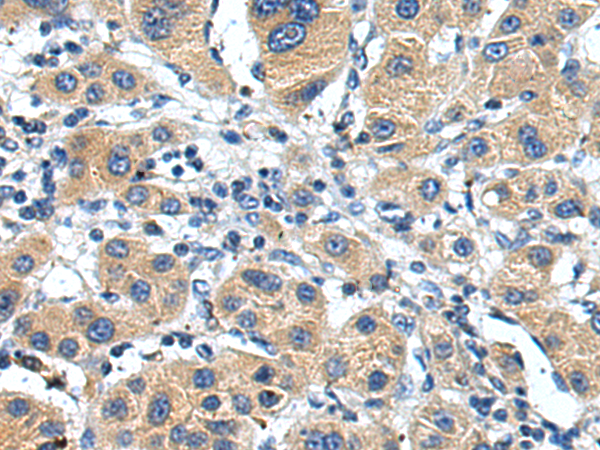
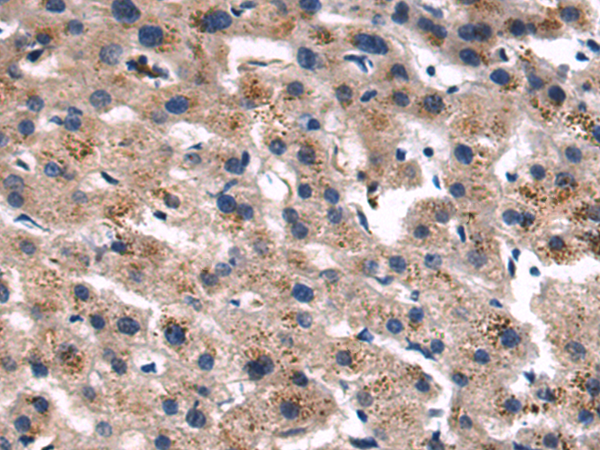

-
分类: 科研抗体货号: P01291别名: LC8; PIN; DLC1; DLC8; LC8a; DNCL1; hdlc1; DNCLC1应用: WB,IHC反应种属: Human, Mouse, Rat
-
分类: 科研抗体货号: P01288别名: ADF; ACTDP; HEL32; bA462D18.2应用: IHC反应种属: Human, Mouse, Rat
-
分类: 科研抗体货号: P01349别名: TOSO; FAIM3应用: WB,IHC反应种属: Human
-
分类: 科研抗体货号: P01420别名: KAT4; KATIV; mitAAT应用: WB,IHC反应种属: Human, Mouse, Rat
-
分类: 科研抗体货号: P01285别名: MLD; DEGS; DES1; Des-1; FADS7; MIG15; DEGS-1应用: WB,IHC反应种属: Human, Mouse, Rat
-
分类: 科研抗体货号: P01346别名: PSAB; FAAH-1应用: IHC反应种属: Human, Mouse, Rat
-
分类: 科研抗体货号: P01418别名: GM130应用: WB,IHC反应种属: Human
-
分类: 科研抗体货号: P01404别名: VKCFD1应用: WB,IHC反应种属: Human, Mouse, Rat
-
分类: 科研抗体货号: P01338别名: ET2; PPET2应用: WB,IHC反应种属: Human
-
分类: 科研抗体货号: P01412别名: GRX; GRX1应用: WB,IHC反应种属: Human, Mouse, Rat

鄂公网安备42018502007531号
鄂公网安备42018502007531号

